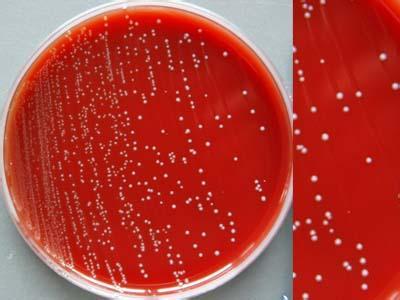

SN/T 2206.3-2009 化妆品微生物检验方法 第3部分:肺炎克雷伯氏菌
1 范围
SN/T 2206的本部分规定了化妆品中肺炎克雷伯氏菌的检验方法。
本部分适用于化妆品中肺炎克雷伯氏菌的检验。
2 规范性引用文件
下列文件中的条款通过SN/T 2206的本部分的引用而成为本部分的条款。凡是注日期的引用文件,其随后所有的修改单(不包括勘误的内容)或修订版均不适用于本部分,然而,鼓励根据本部分达成协议的各方研究是否可使用这些文件的最新版本。凡是不注日期的引用文件,其最新版本适用于本部分。
GB/T 7918. 1化妆品微生物标准检验方法总则
3 材料和设备
3.1 吸管:2.0 mL和10.0 mL,分刻度0.1 mL.。
3.2 三角瓶:150 mL,250 mL。
3.3 培养皿:直径90 mm。
3.4 接种针、接种环。
3.5 载玻片。
3.6 样品处理器具:镊子、剪刀、勺子。
3.7 天平:0 g-600 g,感量0.1g。
3.8 均质器:转速1 000 r/min以上。
3.9 恒温培养箱:36℃±1℃。
3.10 高压灭菌器。
3.11 VITEK全自动微生物鉴定系统或类似设备。
注: VITEK是由法国生物梅里埃公司提供的产品的商品名。给出这一信息是为了方便本标准的使用者,并不表示对该产品的唯一认可。如果其他等效产品具有相同的效果,也可使用这些等效产品。
4 培养基和试剂
4.1 0.85%生理盐水。
4.2 SCDLP液体培养基(见附录A中第A.1章)。
4.3 胆硫乳琼脂(DHL)(见附录A中第A. 2章)。
4.4 营养琼脂斜面培养基(见附录A中第A. 3章)。
4.5 动力半固体琼脂(见附录A中第A. 4章)。
4.6 氧化酶试剂(见附录A中第A. 5章)。
4.7 API 20E生化鉴定试剂条或其他等效产品。
注:API 20E生化鉴定试剂条是由法国生物梅里埃公司提供的产品的商品名。给出这一信息是为了方便本标准的使用者,并不表示对该产品的唯一认可。如果其他等效产品具有相同的效果,也可使用这些等效产品。
更多标准内容点击以下链接获取标准全文: